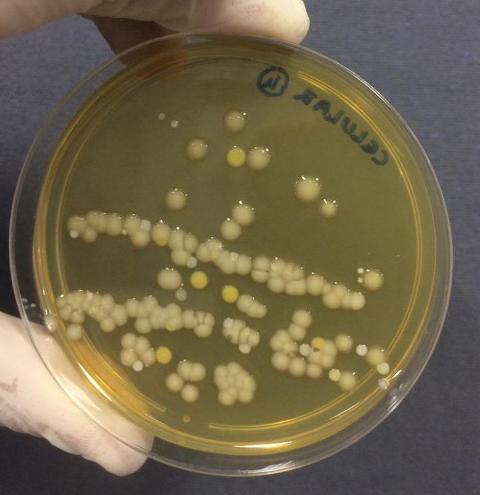

Projeto de extensão sobre estudo de micro-organismos atua remotamente em escola municipal

O projeto de extensão universitária "Micromundo na Escola", do Programa de Microbiologia para Prevenção de Doenças Infecciosas, do Departamento de Microbiologia, Imunologia e Parasitologia - DMIP da UFTM, passou de atividades presenciais para remotas durante a pandemia da Covid-19.
De acordo com o professor Anderson Assunção Andrade, coordenador do Programa, a equipe do projeto está executando ações na Escola Municipal Frei Eugênio, para 150 alunos do 8º ano do ensino fundamental. O projeto foi apresentado aos estudantes e a participação é facultativa. "Estamos aplicando um questionário para levantar o nível de conhecimento dos alunos sobre temas relacionados à microbiologia. O questionário foi dividido em duas partes: a primeira foi encaminhada aos alunos nesta segunda-feira, e a segunda parte será encaminhada na segunda-feira da próxima semana, dia 5", explicou o docente.
Depois o projeto produzirá vídeos apresentando os temas abordados no questionário, que serão encaminhados um a cada semana para a escola. Após todos os temas serem discutidos, o questionário será novamente aplicado para verificar a efetividade das ações.
Os principais objetivos do projeto são explicar o que são micro-organismos, onde eles são encontrados, como podem ser transmitidos aos seres humanos e quais as doenças que causam. Também visa demonstrar a importância de medidas de higiene na redução da população microbiana de superfícies e discutir os resultados no contexto da pandemia do novo coronavírus (SARS-CoV-2).
O Programa de Microbiologia para Prevenção de Doenças Infecciosas do DMIP, ligado ao Instituto de Ciências Biológicas e Naturais - ICBN/UFTM, conta com discentes dos cursos de Biomedicina, Enfermagem, Medicina e Terapia Ocupacional, além de um técnico do Departamento.
Histórico do projeto
A primeira ação do projeto "Micromundo na Escola" ocorreu em março de 2020, no Colégio F.A.S., para 30 alunos do 8º ano do ensino fundamental. A equipe da UFTM fez uma atividade prática presencial para demonstrar a presença de micro-organismos em diferentes superfícies (mãos, celulares, borda de vaso sanitário e torneiras). "Após esta atividade, programamos o retorno à escola na semana seguinte para mostrar os resultados e discuti-los. Porém, o retorno não aconteceu, pois coincidiu com o início da pandemia e suspensão das atividades presenciais. Para compartilhar os resultados com os alunos, decidimos gravar um vídeo e disponibilizá-lo nos canais de comunicação da escola. Foi uma boa oportunidade para discutir a eficiência das medidas de higiene para o controle dos micro-organismos, principalmente no contexto da pandemia pelo novo coronavírus, já que demonstramos que o uso de sabão ou de álcool é capaz de reduzir drasticamente as populações microbianas das superfícies", concluiu o professor Anderson.
Fotos: Divulgação/UFTM
Redes Sociais